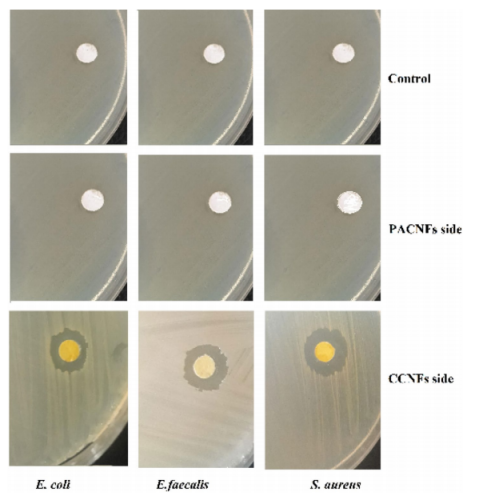

DOI:10.1038/s41598-020-75454-2
本研究旨在开发一种含姜黄素和阿司匹林的不对称引导骨再生(GBR)膜。使用静电纺丝技术制备了该类型的膜,然后通过常规方法对其进行了理化表征。采用紫外分光光度法测定了所制备膜中阿司匹林的释放度。研究者对膜的抗菌活性进行了评估。此外,还评估了所制备的膜对牙髓干细胞(DPSCs)的生物相容性和成骨分化的体外影响,并通过组织学方法评估了膜在犬双侧颌骨缺损处的体内骨再生能力。表征结果表明,该研究制备的膜具有单分散的纳米级纤维、均匀的网状形貌、负表面电荷,且可作为阿司匹林的缓释平台。该膜还显示出对所有受试细菌的抗菌作用。不对称膜中姜黄素和阿司匹林的存在增强了在转录和翻译水平上的成骨潜能。动物试验结果表明,仅28天后,试验区域就完全被新骨填充,而市售膜区域仍然是空的。实验侧的新骨区域上方也有一个软组织层。研究者建议可以将本研究所制备的膜用作GBR膜,以防止软组织占据GBR手术中的骨缺损。此外,这种新型GBR膜的抗菌活性和骨愈合功效有益于手术的进行,同时还可以促进骨再生。

图1.所制备膜的照片。

图2.所制备膜的尺寸分布:(a)阿司匹林负载PLGA纳米颗粒,(b)纳米纤维不对称膜(CCNFs侧),(c)纳米纤维不对称膜(PACNFs侧)。

图3.所制备膜的显微图像:(A)阿司匹林负载PLGA纳米颗粒,(B)不对称膜(CCNFs侧),(C)不对称膜(PACNFs侧),(D)TEM图像显示在CNFs侧的基质中存在PANPs。

图4.所制备材料的ζ电位;(a)阿司匹林负载PLGA纳米颗粒(PANPs),(b)纳米纤维不对称膜(CCNFs侧),(c)纳米纤维不对称膜(PACNFs侧)。

图5.阿司匹林、PLGA、阿司匹林负载PLGA纳米颗粒、姜黄素、胶原蛋白和不对称膜的X射线衍射图(A)和FTIR图(B)。

图6.第1、5、10、15、25和30天时,不对称膜的阿斯匹林释放曲线。
图7.通过检测膜盘周围细菌菌株的生长抑制作用,研究膜对金黄色葡萄球菌、粪肠球菌和大肠杆菌的抗菌作用。

图8.DPSCs在PACFNs和CCNFs膜上培养1、3和7天的增殖情况。星号表示每个时间点测试组和对照组之间的统计学差异(p<0.05)。

图9.在成骨培养基中第7、14和21天在CCNFs和PACNs膜上培养的DPSCs的成骨分化:ALP的活性(a);基因[Runx-2(b)和OCN(c)]的表达;第21天OCN和Runx-2蛋白表达与GAPDH表达的比较(d);OCN(6kDa),Runx-2(55kDa)和GAPDH(37kDa)的蛋白质印迹带(f)。使用三种不同的凝胶来显示OCN、Runx-2和GAPDH蛋白的相对表达(同时保持相似的暴露参数和采集设置)。星号表示对照组和测试组之间的显著差异(p<0.05)。

图10.(a)试验区(覆盖有制备的不对称膜)已完全充满新骨,(b)对照侧(覆盖有市售膜)仍然空着,(c)试验区骨缺损的组织学切片,(d)对照区域骨缺损的组织学切片;UF未填充区,NB新骨,OB老骨。原始放大倍数为40倍。比例尺=500µm。